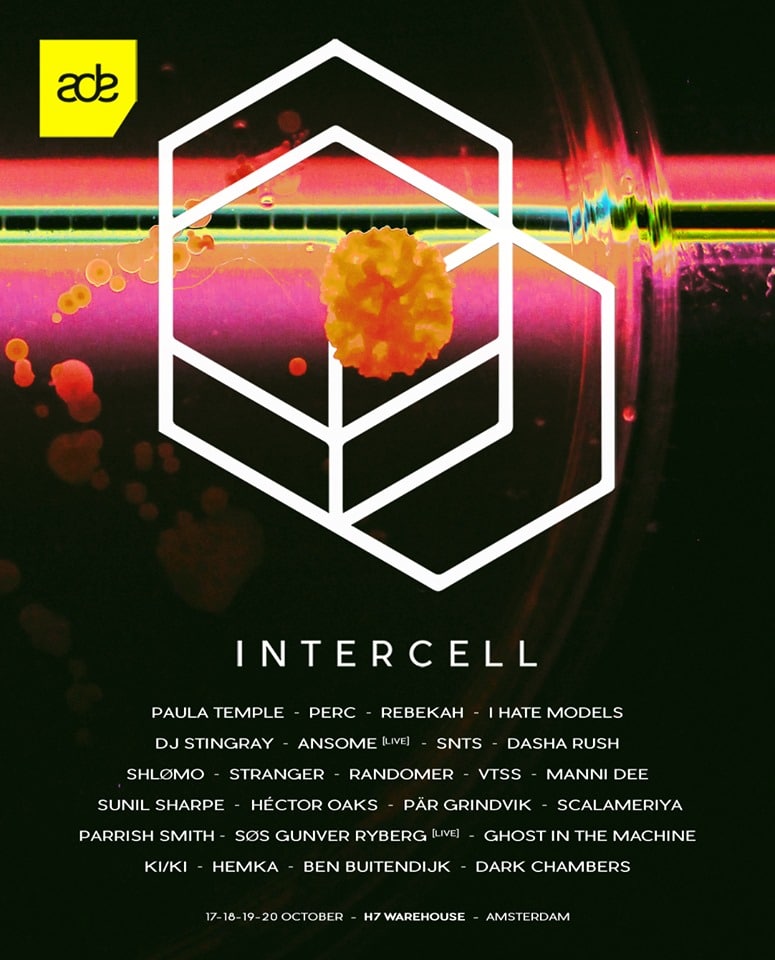

Anyone who follows 6AM Group both here on our site and on social media knows just how much we love the Intercell parties that take over the H7 Warehouse during Amsterdam Dance Event (ADE).
With a focus on the harder, ravier and more discernibly underground styles of techno, the Intercell brand has built a reputation for itself as one of the leading techno event series at ADE, and that is saying a lot given the stellar company they find themselves in every year.
For 2019, Intercell announced a few surprises and confirmed one of the best-received labels in recent years. Perc Trax, which has sold out several times in recent ADE editions, returns on Friday night with label head honcho Perc inviting Ansome (who will perform live), Scalameriya, Manni Dee, Ben Buitendijk and Stranger.
The other three nights find new artists at the helm, all of which are hosting an Intercell night for the first time ever. The four-day Intercell extended weekend begins on Thursday, October 17tha and will be hosted by Rebekah, who has selected DJ Stingray, Parrish Smith, Dasha Rush and Dark Chambers to join the for the occasion.
Saturday night sees another leading artist in techno take control of H7 as Paula Temple showcases her Noise Manifesto label at ADE for the first time ever. While her headlining back-to-back set alongside SNTS may be the highlight, the rest of the lineup featuring ShlĂžmo, SĂS Gunver Ryberg, Ghost In The Machine and HEMKA is pure quality too.
Last but not least, the final Intercell night on Sunday, October 20th will be headed up by I Hate Models, who will be joined by Body Sushi (Randomer & VTSS), Hector Oaks, Sunil Sharpe, PĂ€r Grindvik and Ki / Ki.
One of our favorite elements of the Intercell experience, besides the well-curated lineups, is the production. Carefully-curated lighting and mind-blowing visuals by JAMES LOST make these some of the best events in the whole ADE calendar, period. We have been so captivated by the visuals that we have now flown Amsterdam’s JAMES LOST out to VJ two of our COMPOUND events in Los Angeles.
If you pay attention to our events right here in LA, you will know that in the last year we have hosted Intercell headliners Perc (who returns on September 1st 2019 for REFORM), Rebekah and I Hate Models, as well as other artists invited to play these four showcases including Randomer (he is debuting for our WORK series this Saturday here in LA), SNTS (who returns September 27th here in LA), Ansome and Manni Dee. Needless to say, this translates to one simple fact: we love what Intercell is doing, and will be in attendance throughout the weekend to experience the events for ourselves.
Tickets for all four events, and more information can be found HERE
Connect with Intercell: Facebook | Instagram | SoundCloud